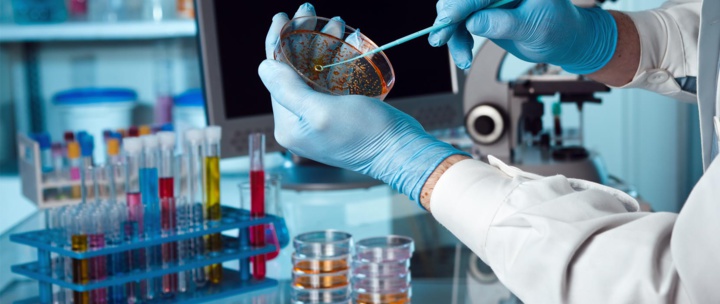
Recherches biomédicales : le décret d’application publié au B.O Recherches biomédicales : le décret d’application publié au B.O

Adopté en mars dernier en Conseil de gouvernement, ce texte devrait permettre non seulement d’organiser et d’encadrer la recherche et les essais cliniques au Royaume, mais aussi de soutenir la mise en place d’un écosystème qui leur sera dédié.
Ce texte vise ainsi à déterminer les modalités de recueil et du retrait du consentement des personnes participant aux recherches biomédicales et de recrutement des personnes saines qui se prêtent à la recherche biomédicale, en plus des modalités d’indemnisation.
Il fixe aussi les comités régionaux de protection des personnes participant aux recherches biomédicales, leur nombre, le ressort territorial et le siège de chacun et la composition et les modalités de fonctionnement de ces comités ainsi que les modalités de désignation de leurs membres.
Le texte détermine également les modalités d’autorisation, de suspension et de retrait des autorisations sur les sites des recherches biomédicales et les modalités de la demande d’autorisation pour la recherche biomédicale et sa modification, outre les conditions de réalisation des recherches biomédicales.
Pourquoi investir dans la recherche biomédicale ?
Manifestement, le renforcement de la loi 28-13 par ce décret intervient dans un contexte où la recherche biomédicale est aujourd’hui l’objet d’une compétition internationale intense. En effet, surtout en cette période difficile marqué par la crise sanitaire, il est établi que les investissements en recherche biomédicale impactent positivement les pays sur le plan sanitaire, économique et social : amélioration de l’accès des patients au progrès thérapeutique, élévation de la qualité des soins, création de sociétés prestataires de service, renforcement de l’employabilité hautement qualifiée, etc.
Afin d’attirer ces investissements, les pays, à l’image du Maroc, mettent en place de nouvelles réglementations rigoureuses et souples dans leur application. Celles-ci assurent à la fois le renforcement de la protection des personnes et l’exigence d’une rigueur méthodologique et scientifique associée à une qualité garantissant la pertinence, la robustesse et l’intégrité des données.
Ces nouvelles réglementations renforcent aussi la transparence et élargissent l’accès aux données depuis leur autorisation jusqu’à la publication de leurs résultats. Il faut souligner aussi que si le Maroc mise sur cette industrie, c'est parce que cette dernière pourrait générer des recettes importantes. D’après les experts du secteur, elle pourrait causer un chiffre d’affaires avoisinant le milliard de dirhams au Maroc.
La recherche biomédicale est un domaine d’études qui vise à améliorer les connaissances en matière de santé. Pour ce faire, elle se base notamment sur le recueil, chez des personnes volontaires, d’informations à caractère biologique et/ou médical.
Ce texte vise ainsi à déterminer les modalités de recueil et du retrait du consentement des personnes participant aux recherches biomédicales et de recrutement des personnes saines qui se prêtent à la recherche biomédicale, en plus des modalités d’indemnisation.
Il fixe aussi les comités régionaux de protection des personnes participant aux recherches biomédicales, leur nombre, le ressort territorial et le siège de chacun et la composition et les modalités de fonctionnement de ces comités ainsi que les modalités de désignation de leurs membres.
Le texte détermine également les modalités d’autorisation, de suspension et de retrait des autorisations sur les sites des recherches biomédicales et les modalités de la demande d’autorisation pour la recherche biomédicale et sa modification, outre les conditions de réalisation des recherches biomédicales.
Pourquoi investir dans la recherche biomédicale ?
Manifestement, le renforcement de la loi 28-13 par ce décret intervient dans un contexte où la recherche biomédicale est aujourd’hui l’objet d’une compétition internationale intense. En effet, surtout en cette période difficile marqué par la crise sanitaire, il est établi que les investissements en recherche biomédicale impactent positivement les pays sur le plan sanitaire, économique et social : amélioration de l’accès des patients au progrès thérapeutique, élévation de la qualité des soins, création de sociétés prestataires de service, renforcement de l’employabilité hautement qualifiée, etc.
Afin d’attirer ces investissements, les pays, à l’image du Maroc, mettent en place de nouvelles réglementations rigoureuses et souples dans leur application. Celles-ci assurent à la fois le renforcement de la protection des personnes et l’exigence d’une rigueur méthodologique et scientifique associée à une qualité garantissant la pertinence, la robustesse et l’intégrité des données.
Ces nouvelles réglementations renforcent aussi la transparence et élargissent l’accès aux données depuis leur autorisation jusqu’à la publication de leurs résultats. Il faut souligner aussi que si le Maroc mise sur cette industrie, c'est parce que cette dernière pourrait générer des recettes importantes. D’après les experts du secteur, elle pourrait causer un chiffre d’affaires avoisinant le milliard de dirhams au Maroc.
La recherche biomédicale est un domaine d’études qui vise à améliorer les connaissances en matière de santé. Pour ce faire, elle se base notamment sur le recueil, chez des personnes volontaires, d’informations à caractère biologique et/ou médical.